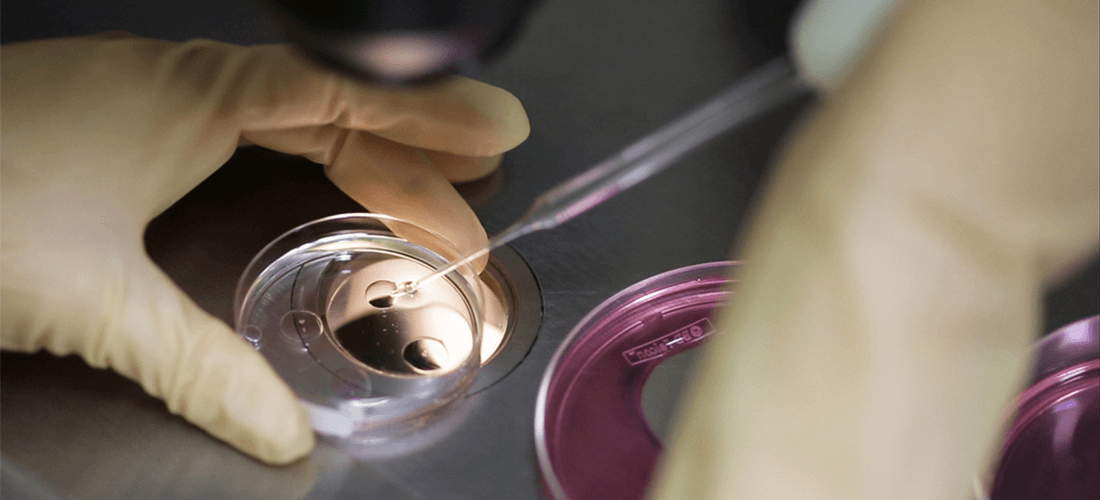
What is Embryo Donation?

For donation cycles, hormone treatment stimulates the egg donors during the preparation for an egg collection. First our expert team collects the eggs from a donor, and the eggs are injected with sperm from the father. The fertilized embryos are then transferred to the recipient mother after they have been prepared in synchronization with the donor. This method of IVF has been used widely for 30 years.

Egg Donation
Egg Donation at Cyprus IVF Center: A Path to Motherhood “Motherhood comes through love, not DNA.” At Cyprus IVF Center, Egg Donation offers a life-changing solution for women unable to conceive with their own eggs. Egg Donation cycles involve hormone
Read more
Embryo Donation
What is Embryo Donation? The process of an embryo donation involves fertilizing the donated eggs with the donated sperm and then injecting it into the female that will carry the baby. Tests Before Embryo Donations Physical examinations for history and background checks
Read more
Gender Selection – PGD
What is PGD? PGD (Preimplantation Genetic Diagnosis) is a technique that is used to evaluate all chromosomes of the embryo before their transfer into the womb. For the genetic selection to be guaranteed, it should be done on the 5th
Read more
Infertility and IVF
What is Infertility? Infertility is defined as the failure to get pregnant after one year of unprotected, well timed sexual intercourse. Research has found that around 40% of infertility is caused by female factors, 40% of male factors, and 20%
Read more
IMSI Technology
IMSI or Intracytoplasmic Morphologically selected Sperm Injection technology allows to perform morphological analyses of sperm at the highest level compared to standard IVF and microinjection applications. This analysis allows for the microinjection of the sperm without any damage to the
Read moreWhat You Need To Know About Cyprus And Accommodation
Patients from all over the world have the opportunity to be treated whilst on vacation. You can have your annual holiday with the benefit of returning home with the joy of having a baby. All you have to do is get in touch, sit back and relax while we help you with accommodation bookings, airport transfers and clinic to hotel transfers.